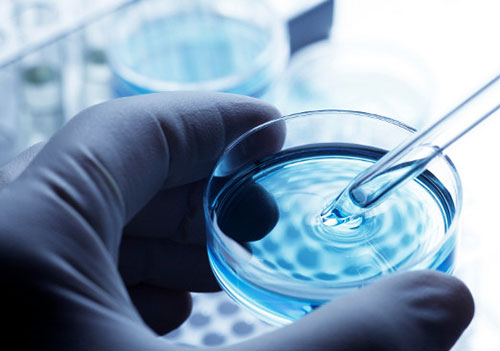

“Ti taglio la testa”: 29enne minaccia la moglie con un coltello. Arrestato

Durante la lite l'uomo ha distrutto numerosi suppellettili e fondato la porta, poi dopo aver impugnato un coltello se n'è andato dicendo alla moglie che sarebbe tornato per «tagliarle la testa».
canale WhatsApp
La Polizia di Stato ha arrestato un 29enne di Iglesias, pluripregiudicato, per i reati di maltrattamenti in famiglia e danneggiamento.
Intorno alle ore 19.30 di ieri, personale di polizia è intervenuto a Iglesias per una richiesta di intervento arrivata da parte di una donna che riferiva di essere stata minacciata dal coniuge.
I poliziotti hanno raggiunto l’indirizzo contattando la richiedente che ha riferito che, poco prima, a seguito di un’animata discussione con il marito avvenuta in casa, lo stesso ha dato in escandescenza rompendo numerosi suppellettili e sfondando una porta. Nel corso della lite l’uomo la minacciava con un grosso coltello da cucina, per poi allontanarsi urlando che sarebbe tornato più tardi per tagliarle la testa.
Gli agenti, vista la delicatezza della segnalazione e accertato quanto indicato dalla donna, oltre alle precedenti segnalazioni per maltrattamenti fatte dalla donna, sono rimasti nei pressi dell’abitazione e, verso le 20.30, la vittima ha richiamato il 113 segnalando nuovamente la presenza dell’uomo che stava tentando di entrare sferrando calci alla porta di ingresso e hanno immediatamente raggiunto la via bloccando il 29enne che, alla vista dell’equipaggio, ha provato a dileguarsi.
Dopo gli atti di rito, è stato accompagnato nella Casa Circondariale di Uta.

© RIPRODUZIONE RISERVATA
Arbatax, valori dell’acqua nella norma. La conferma anche da parte della ASSL: “E’ potabile”
Questa mattina l’Assl ha comunicato gli esiti dei propri controlli al Comune per consentire la revoca dell’ordinanza di non potabiltià
canale WhatsApp
Il dipartimento di prevenzione del Sian dell’Assl di Lanusei conferma il pieno rispetto di tutti i parametri dell’acqua distribuita ad Arbatax. I risultati delle analisi effettuati dall’Azienda ospedaliera sono in linea con quanto già verificato dai laboratori certificati di Abbanoa la scorsa settimana che già segnalavano la presenza di valori a norma. Questa mattina l’Assl ha comunicato gli esiti dei propri controlli al Comune per consentire la revoca dell’ordinanza di non potabiltià
Nei giorni scorsi il Sian aveva segnalato al Comune un fuori norma relativo a un solo punto di campionamento mentre in tutti gli altri punti di prelievo nel territorio di Tortolì confermavano il rispetto di tutti i parametri. Un’anomalia dovuta forse allo scarso utilizzo dell’acqua, tipico in questo periodo, nel punto di campionamento di Arbatax che ha quindi determinato uno scarso ricambio della risorsa idrica esclusivamente nel tratto di rete interessato. Le operazioni eseguite e le analisi effettuate anche dall’Assl confermano nuovamente il rispetto dei parametri anche in questo punto.

© RIPRODUZIONE RISERVATA